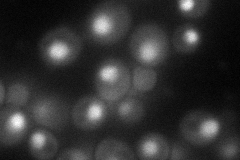
YKR034W

View description
Negative regulator of genes in multiple nitrogen degradation pathways; expression is regulated by nitrogen levels and by Gln3p; member of the GATA-binding family, forms homodimers and heterodimers with Deh1p
Localization:
Intensity:
Fold change:
Significance:
-
C’ GFP library in SD

below threshold16.2 -
N' NOP1pr-GFP in SD
nucleus73.7654 -
N' TEF2pr-mCherry in SD

nucleus52.8016 -
N' NATIVEpr-GFP in SD

below threshold20.0265 -
N' TEF2pr-VC and Cyto-VN in SD

punctate,nucleus26.5696 -
C’ GFP library in SD+DTT

cytosol17.771.09No -
C’ GFP library in SD+H2O2

cytosol17.31.06No -
C’ GFP library in Starvation Media

nucleus30.661.89No -
C’ GFP library on the background of Pup2-DaMP

below threshold -
C’ GFP library on the background of CCT mutant

below threshold18.26221.12728No
